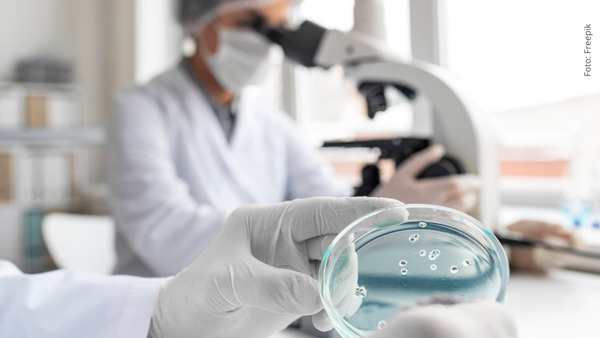
Científicos descubren molécula con IA que podría tratar el cáncer de colon Científicos descubren molécula con IA que podría tratar el cáncer de colon

¿Qué es la perimenopausia, la condición que llevó a Margarita Ortega al hospital?
La presentadora Margarita Ortega fue hospitalizada recientemente debido a complicaciones de salud. ¡VIDEO aquí!
La reconocida actriz y presentadora Margarita Ortega ha compartido recientemente un mensaje profundo y honesto sobre su estado de salud, conmoviendo a sus seguidores y abriendo una conversación importante sobre el bienestar físico y emocional de las mujeres en etapa de transición hormonal.
La también periodista, reconocida por su trabajo en televisión y en espacios informativos de gran audiencia, atraviesa un momento complejo en su vida personal.
¿Por qué Margarita Ortega fue hospitalizada?
A través de sus redes sociales, Margarita reveló que ha estado lidiando con un problema serio en su columna vertebral, el cual ha afectado su rutina diaria y la ha obligado a hacer pausas inesperadas.
Con un mensaje reflexivo, la presentadora describió la lucha constante con su cuerpo: “Mi columna y yo. Yo le insisto todos los días sobre el camino que recorremos juntas (...) Me enseña, pero somos igual de tercas”, escribió, dejando ver la dimensión emocional y física de esta batalla.
¿Qué otros problemas de salud enfrenta Margarita Ortega?
Además del tema en su columna, Ortega también atraviesa la perimenopausia, una etapa de cambios hormonales que muchas mujeres experimentan antes de la menopausia, y que suele estar acompañada de síntomas intensos y, muchas veces, invisibles para los demás.
¿Qué es la perimenopausia y cómo afecta?
La perimenopausia es el proceso de transición previo al fin definitivo del ciclo menstrual. Aunque cada cuerpo lo vive de forma distinta, puede generar alteraciones significativas en el día a día:
- Ciclos menstruales irregulares
- Sofocos y sudoraciones nocturnas
- Insomnio o dificultad para descansar
- Cambios de ánimo, desde ansiedad hasta tristeza sin razón aparente
- Sequedad vaginal y molestias durante las relaciones sexuales
- Aumento de grasa abdominal y pérdida de tono muscular
- Problemas de concentración o memoria
¿Cómo cuidar tu salud durante la perimenopausia?
Aunque la perimenopausia no se puede evitar, sí hay formas de sobrellevarla con mayor bienestar. Aquí algunos consejos prácticos:
- Visitar a un especialista: El diagnóstico y acompañamiento profesional es clave.
- Registrar los síntomas: Llevar una bitácora ayuda a identificar patrones.
- Moverte y alimentarte mejor: Hacer ejercicio y comer saludablemente alivia muchos malestares.
- Dormir bien: El descanso es fundamental en esta etapa.
- Tener apoyo emocional: Hablar con personas cercanas o con un terapeuta puede marcar la diferencia.
¿Por qué hablar de la perimenopausia es importante?
Historias como la de Margarita Ortega ayudan a visibilizar procesos que muchas mujeres viven en silencio. Compartir estos cambios con franqueza no solo genera empatía, sino que puede inspirar a otras a buscar ayuda, reconocer sus síntomas y priorizar su bienestar físico y mental.
La salud femenina merece espacio en la conversación pública y la valentía de figuras como Margarita abre el camino.
Unirse a canal de Whatsapp de SuperLike